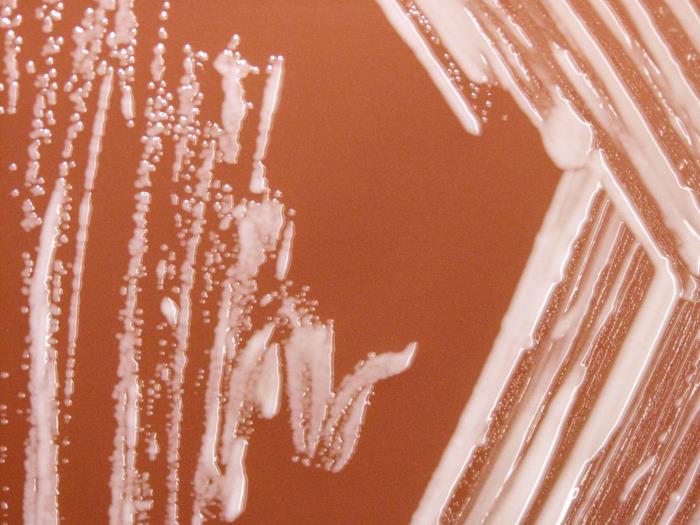

Brucella pertenece a la familia Brucellaceae. Son bacilos cortos o cocobacilos Gram negativo, con tamaño entre 0,5-0,7 x 0,6-1,5 micras, aerobios, inmóviles, no formadores de esporas ni cápsulas y de crecimiento lento.
Se trata de parásitos intracelulares facultativos, pudiendo resistir en las células fagocitarias.
Algunas especies de Brucella incluyen biovariedades, habiéndose informado cinco biotipos para B. suis, tres para B. melitensis y hasta nueve para B. abortus. B. melitensis es considerada la más peligrosa para el hombre.
Dado su potencial infectivo, algunas especies de Brucella podrían ser utilizadas en un ataque bioterrorista, estando incluidas en la lista de agentes potenciales de bioterrorismo (categoría B, agentes de segunda prioridad).
Viabilidad, propagación y transmisión
Reservorio
Cánidos (principalmente domésticos).
Hospedadores
Humanos, cánidos, pumas, ocelotes, jaguares cautivos, bovinos (17).
Dosis Infectiva Mínima (DIM)
De 10 a 100 microorganismos por inhalación son suficientes para producir la enfermedad.
Supervivencia ambiental
Brucella puede sobrevivir durante más de dos meses en agua a 20ºC, dos meses en el suelo y pasto fresco en un ambiente húmedo, hasta 8 meses en estiércol y muchos meses en sustratos secos (heno, polvo, lana, equipos y útiles de trabajo, etc.). La supervivencia es más prolongada cuando la temperatura es baja, principalmente cuando se encuentra por debajo del punto de congelación.
También puede sobrevivir durante meses en órganos y carcasas de animales, o en sangre a 4ºC. En la carne sobrevive durante periodos de tiempo muy cortos, salvo si está congelada, en cuyo caso puede sobrevivir durante años.
Formas de resistencia
No presenta formas de resistencia.
Mecanismo de propagación y transmisión
La transmisión de Brucella se puede producir por el aire mediante la inhalación de bioaerosoles, así como por contacto directo de las mucosas (conjuntiva, orofaríngea, nasal), y la piel lesionada con tejidos, sangre, orina, secreciones vaginales, fetos abortados y, en especial, placentas de animales enfermos (zoonosis).
También se puede transmitir por inoculación accidental de la vacuna viva atenuada para Brucella.
Además, se puede transmitir por ingestión de leche cruda, productos lácteos (queso) sin pasteurizar y carne cruda o poco cocinada, procedentes de animales infectados.
Por último, para algunas especies se ha descrito la transmisión vertical de la madre al hijo por vía transplacentaria y, rara vez, a través de la lactancia (1) (2).
La transmisión de persona a persona es extremadamente rara.
Las infecciones por B. canis han ocurrido después de un contacto cercano con perros, especialmente animales que recientemente abortaron o dieron a luz, o después de la exposición a grandes cantidades del organismo en laboratorios (17).
Vías de entrada
Respiratoria. Mucosas. Percutánea. Digestiva.
Distribución geográfica
Norteamérica, Centroamérica y Suramérica, Australia, partes de Asia, África y Europa (17).
Efectos sobre la salud
Grupo de riesgo
3
(Ver Anexo II RD 664/1997 )Infección
Brucelosis (fiebre de Malta, fiebre ondulante, fiebre mediterránea): se han notificado pocos casos de brucelosis en humanos por B. canis y la mayoría han sido leves. La brucelosis causada por B. canis es semejante a la causada por otras especies de Brucella. Los casos clínicos publicados asociados con B. canis van desde fatiga leve o fatiga y fiebre intermitente como único síntoma, a una enfermedad febril con fatiga, malestar, náuseas, escalofríos, sudores nocturnos y dolor de cabeza. Fiebre de origen desconocido, a veces prolongada, fue el síndrome de presentación en algunos individuos. Agrandamiento del bazo y/o del hígado y aumento de enzimas hepáticas se notificaron en varios casos. Pérdida de peso, anemia, ganglios linfáticos agrandados y dolor abdominal también han sido documentados. Las náuseas, los vómitos y la diarrea se han descrito, especialmente en niños, y un individuo informó de tos persistente, dolor de garganta y picor conjuntival (además de sudores nocturnos, dolor de cabeza, letargo y mialgia). Complicaciones graves, incluida la endocarditis también se han notificado en algunos casos (17).
Actualmente no hay informes de muertes causadas por B. canis. Las estimaciones de la tasa de letalidad por enfermedades no tratadas causadas por otras especies de Brucella, incluido el organismo altamente virulento B. melitensis, suelen oscilar entre el 1% y el 2% o menos.
Efectos alérgicos (Ver Anexo II RD 664/1997 ) / (Ver Allergen )
No se han descrito
Efectos tóxicos (Ver Anexo II RD 664/1997 )
No se han descrito
Efectos cancerígenos (Ver International Agency for Research On Cancer - IARC )
No se han descrito
Efectos en la maternidad
No se han descrito
Enfermedad
| CIE-10 | Nombre | Enfermedad de Declaración Obligatoria |
|---|---|---|
| A23.3 | Brucelosis debida a Brucella canis | Sí |
Actividades laborales con riesgo
Clasificación Nacional de Actividades Económicas (CNAE)
| CNAE 2009 | Descripción |
|---|---|
| A0141 | Explotación de ganado bovino para la producción de leche |
| A0142 | Explotación de otro ganado bovino y búfalos |
| A0143 | Explotación de caballos y otros equinos |
| A0144 | Explotación de camellos y otros camélidos |
| A0145 | Explotación de ganado ovino y caprino |
| A0146 | Explotación de ganado porcino |
| A0148 | Otras explotaciones de ganado |
| A0150 | Producción agrícola combinada con la producción ganadera |
| A0162 | Actividades de apoyo a la ganadería |
| A0170 | Caza, captura de animales y servicios relacionados |
| C1011 | Procesado y conservación de carne, excepto volatería |
| C1013 | Elaboración de productos cárnicos y de volatería |
| G4632 | Comercio al por mayor de carne, productos cárnicos; pescado y productos del pescado |
| N7210 | Investigación y desarrollo experimental en ciencias naturales y técnicas |
| N7500 | Actividades veterinarias |
| O8130 | Actividades de jardinería |
| R8699 | Otras actividades sanitarias n.c.o.p. |
| S9141 | Actividades de los jardines botánicos y los parques zoológicos |
Clasificación Nacional de Ocupaciones (CNO)
| CNO 2011 | Descripción |
|---|---|
| 2130 | Veterinarios |
| 2210 | Profesores de universidades y otra enseñanza superior (excepto formación profesional) |
| 2421 | Biólogos, botánicos, zoólogos y afines |
| 3141 | Técnicos en ciencias biológicas (excepto en áreas sanitarias) |
| 3313 | Técnicos en anatomía patológica y citología |
| 3314 | Técnicos en laboratorio de diagnóstico clínico |
| 3327 | Ayudantes de veterinaria |
| 5893 | Cuidadores de animales y adiestradores |
| 6120 | Trabajadores cualificados en huertas, invernaderos, viveros y jardines |
| 6201 | Trabajadores cualificados en actividades ganaderas de vacuno |
| 6202 | Trabajadores cualificados en actividades ganaderas de ovino y caprino |
| 6203 | Trabajadores cualificados en actividades ganaderas de porcino |
| 6205 | Trabajadores cualificados en la avicultura y la cunicultura |
| 6209 | Trabajadores cualificados en actividades ganaderas no clasificados bajo otros epígrafes |
| 6430 | Trabajadores cualificados en actividades cinegéticas |
| 7701 | Matarifes y trabajadores de las industrias cárnicas |
| 8160 | Operadores de máquinas para elaborar productos alimenticios, bebidas y tabaco |
| 9512 | Peones agrícolas en huertas, invernaderos, viveros y jardines |
| 9520 | Peones ganaderos |
| 9530 | Peones agropecuarios |
Prevención y control
Desinfectantes
La mayoría de los desinfectantes. Hipoclorito sódico al 1 %, etanol al 70 %, soluciones alcohol/yodo, glutaraldehido, formaldehido, xileno, isopropanol, desinfectantes fenólicos.
Brucella se inactiva rápidamente con pH ácido < 3.5 (17).
Inactivación física
Inactivación por calor húmedo a 121 ºC durante al menos 15 minutos y por calor seco a 160-170 ºC durante al menos 1 hora. También por radiación gamma, radiación ultravioleta y pasteurización.
Antimicrobianos
Tetraciclinas (doxiciclina), estreptomicinas, trimetoprim-sulfametoxazol (TMP-SMX), rifampicina y gentamicina.
Vacunación
No disponible
Medidas preventivas generales
Vacunación, control sanitario de los animales y sacrificio del ganado infectado, cumpliendo con lo dispuesto en el Real Decreto 2611/1996, de 20 de diciembre, por el que se regulan los programas nacionales de erradicación de enfermedades de los animales.
Mantener los locales en condiciones adecuadas de ventilación, limpieza y desinfección.
Evitar la generación de aerosoles.
Evitar ingerir productos de riesgo, como leche, productos lácteos no pasteurizados o carne cruda.
Seguir unas correctas prácticas de higiene en el trabajo: aseo personal, prohibición de comer en zonas de riesgos, evitar la exposición de heridas abiertas. Utilización de ropa de trabajo y equipos de protección individual adecuados.
Control de vectores (desinsectación, desratización)
Adecuada gestión de residuos infecciosos según la legislación específica.
Precauciones en centros sanitarios
En hospitales o centros sanitarios, adoptar las Precauciones Estándar.
EPI
Protección respiratoria: mascarillas autofiltrantes tipo FFP2, preferiblemente FFP3 para operaciones en las que se generen gran cantidad de bioaerosoles contaminados.
Protección de las manos: guantes (incluidas las mangas) impermeables, cuando sea inevitable el contacto directo con animales o materiales infecciosos.
Mangas, batas, mandilones o delantales impermeables durante operaciones de obstetricia o contacto con animales potencialmente infecciosos.
Protección ocular o facial: gafa de protección de montura universal en caso de riesgo de contacto accidental mano/guante contaminado-ojo, o pantalla de protección facial (símbolo de marcado en montura: 3) en caso de riesgo de exposición a salpicaduras, o gafa de protección de montura integral con hermeticidad frente a partículas (símbolo de marcado en montura: 4 o 5), en caso de riesgo de exposición a bioaerosoles.
Seguridad en laboratorio
Nivel de contención: 2/3
Los principales riesgos son la inhalación de bioaerosoles, el contacto directo de la piel y las mucosas con cultivos del agente o muestras de animales infectados, y la inoculación percutánea accidental.
Las muestras o especímenes más peligrosos son: cultivos, sangre, tejidos, líquido cefalorraquídeo, placentas, fetos, orina, secreciones vaginales, excreciones pulmonares, heces y leche (3) (16).
Se requieren las prácticas y la contención de un nivel 2 de bioseguridad cuando se manipulen materiales clínicos de origen animal o humano, y de un nivel 3 de bioseguridad para la manipulación de cultivos, trabajos con tejidos o productos de partos o abortos potencialmente infectados y estudios experimentales con animales infectados. También es recomendable un nivel 3 cuando se trabaje con grandes cantidades de muestra o la práctica implique riesgo alto de generación de bioaerosoles (4).
Bibliografía
- Alsaif, M., Dabelah, K., Featherstone, R., & Robison J. L. (2018). Consequences of brucellosis infection during pregnancy: a systematic review of the literature. International journal of infectious diseases, 73,18-26. DOI: 10.1016/j.ijid.2018.05.023.
- Bosilkovski, M., Arapović, J., & Keramat, F. (2020). Human brucellosis in pregnancy - an overview. Bosnian journal of basic medical sciences, 20(4), 415–422. DOI: 10.17305/bjbms.2019.4499.
- Centers for Disease Control and Prevention (CDC). (2019). Guideline for isolation precautions: preventing transmisión of infectious agents in healthcare settings. CDC: Infection control.
- Centers for Disease Control and Prevention (CDC). (2020). Biosafety in microbiological and biomedical laboratories (6th ed.).
- Centers for Diasease Control and Prevention (CDC). (2021). Brucellosis.
- Comisión de Salud Pública del Consejo Interterritorial del Sistema Nacional de Salud. Ministerio de Sanidad y Consumo. (2001). Protocolo de vigilancia sanitaria específica para los/as trabajadores/as expuestos a agentes biológicos.
- Institut National de Recherche et de Sécurité (INRS). (2023). Brucella canis. BAse d'OBservation des Agents Biologiques (BAOBAB).
- Institut National de Recherche et de Sécurité (INRS). (2023). Brucellose. Base de donées EFICATT.
- Instituto de Salud Carlos III (ISCIII). (2015). Protocolo de vigilancia de brucelosis. En Protocolos de la Red Nacional de Vigilancia Epidemiológica (RENAVE) (28-35).
- Instituto Nacional de la Seguridad Social. (2020). Guía de ayuda para la valoración del riesgo laboral durante el embarazo (3ª ed.).
- Instituto Nacional de Seguridad e Higiene en el Trabajo (INSHT). (2011). Directrices para la evaluación de riesgos y protección de la maternidad en el trabajo.
- Instituto Nacional de Seguridad y Salud en el Trabajo (INSST). Notas Técnicas de Prevención (NTP): 376, 411, 468, 571, 771, 901 y 938.
- Ministerio de Defensa. (2010). 06 Monografías del SOPT: Detección e identificación de agentes de guerra biológica. Estado del arte y tendencia futura.
- Public Health Agency of Canada. (2011). Brucella spp. (B. abortus, B. canis, B. melitensis, B. suis). Pathogen Safety Data Sheets.
- Servicio Riojano de Salud. (2008). Precauciones de aislamiento en centros sanitarios.
- The Center for Food Security and Public Health (CFSPH). (2009). Brucelosis. CFSPH-Español: Fichas de las enfermedades.
- The Center for Food Security and Public Health (CFSPH). (2018). Brucellosis: Brucella canis. CFSPH: Disease information.
- World Health Organization, Food and Agriculture Organization of the United Nations & World Organisation for Animal Health. (2006). Brucellosis in humans and animals.